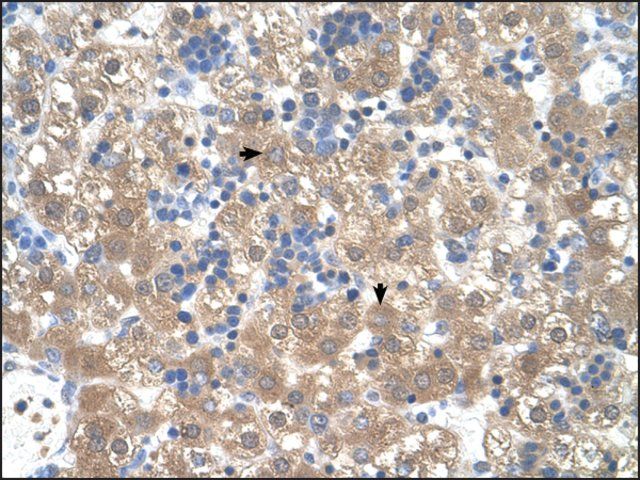

ن؛§ه“پهگچ称9ü/div>
Anti-PEG3 antibody produced in rabbit
ZSCAN24
KIAA0287
PEG3
Zinc finger and SCAN domain-containing protein 24
Paternally-expressed gene 3 protein
ن؛§ه“پن»‹ç»چï¼™ü/div>
ن؛§ه“پ说وکژ
特ه¼‚و€?/p>
The antibody detects endogenous levels of total PEG3 protein.
ه…چç–«هژü/p>
Synthesized peptide derived from internal of human PEG3.
特点ه’Œن¼کهٹ¾ü/p>
Evaluate our antibodies with complete peace of mind. If the antibody does not perform in your application, we will issue a full credit or replacement antibody. Learn more.
ه¤–ه½¢
Rabbit IgG in phosphate buffered saline (without Mg2+ and Ca2+), pH 7.4, 150mM NaCl, 0.02% sodium azide and 50% glycerol.
ه…چè´£ه£°وکژ
Unless otherwise stated in our catalog or other company documentation accompanying the product(s), our products are intended for research use only and are not to be used for any other purpose, which includes but is not limited to, unauthorized commercial uses, in vitro diagnostic uses, ex vivo or in vivo therapeutic uses or any type of consumption or application to humans or animals.
ن؛§ه“پو€§è´¨
| ç”ں物و¥و؛گ |
rabbit |
| è´¨é‡ڈو°´ه¹³ |
100 |
| وٹ—ن½“ه½¢ه¼ڈ |
affinity isolated antibody |
| antibody product type |
primary antibodies |
| ه…‹éڑ† |
polyclonal |
| ه½¢ه¼ڈ |
buffered aqueous solution |
| هˆ†هگé‡ژü/td> |
181 kDa |
| species reactivity |
human |
| وµ“ه؛¦ |
1.0 mg/mL |
| technique(s) |
western blot: 1:500-1:3000 (Cell Lysate) |
| هگŒن½چç´?ن؛ڑه‹ |
IgG |
| 登记هڈ¶ü/td> |
NP_060268.2 |
| UniProt登记هڈ¶ü/td> |
Q9GZU2 |
| è؟گ输 |
wet ice |
| ه‚¨هکو¸©ه؛¦ |
?20â„‚ü/td> |
| Gene Information |
human ... PEG3(5178) |
ه®‰ه…¨ن؟،وپ¯
| ه‚¨هکهˆ†ç±»ن»£ç پ |
12 - Non Combustible Liquids |
| WGK |
WGK 1 |
| é—ھ点(F) |
Not applicable |
| é—ھ点(C) |
Not applicable |
 m.cnreagent.com
m.cnreagent.com